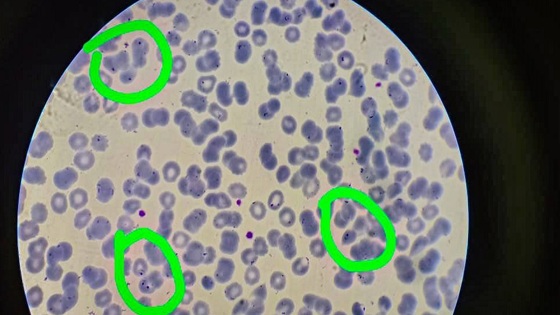

В ОКБ имени Семашко госпитализировали рязанца-геолога с тропической малярией
Как сообщили в соцсетях представители медицинского учреждения, мужчину привезли с лихорадкой. Что было причиной такого состояния 37-летнего рязанца, сразу определить не удалось.
Поставить диагноз помог анализ крови. "Обнаружены мелкие кольцевидные трофозойты внутри поражённых эритроцитов. Морфологически выделен вид тропической малярии, вызванной Pl. Falciparum", - таков был вердикт.
Оказалось, что пациент работает геологом, и не так давно был в Африке. Там он вполне мог заразиться экзотической для наших мест болезнью.
Врачи смогли оперативно оказать рязанцу всю необходимую помощь благодаря быстрой и правильной постановке диагноза.